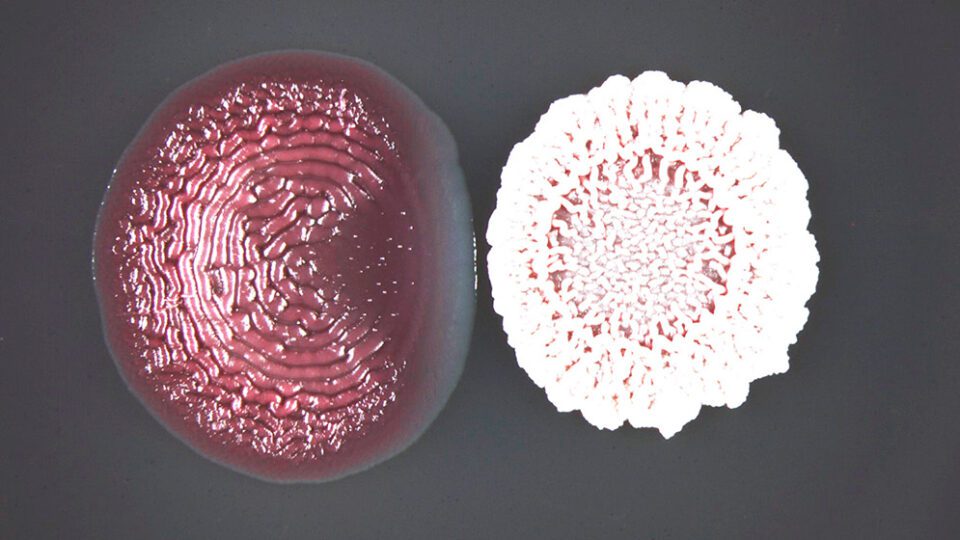

Científicos argentinos buscan entender cómo su uso afecta a los biofilms, el modo de vida más resistente de los microorganismos, responsable de casi el 80 % de las infecciones persistentes. Los resultados apuntan a brindar nuevas herramientas para combatirlas con mayor eficiencia.
Las bacterias, los primeros seres vivos en habitar la Tierra, aunque invisibles al ojo humano, son la población de organismos más numerosa del planeta. Conformados por una sola célula y expuestos a un entorno cambiante lleno de amenazas han desarrollado diversos mecanismos que les permiten resistir, tolerar y sobrevivir a condiciones inhóspitas como las temperaturas extremas, ambientes hiper salinos o la presencia de sustancias químicas que interfieren con procesos fundamentales de su fisiología: los antibióticos.
Aunque muchos de los mecanismos desarrollados por las bacterias para resistir a los antibióticos son de base genética e implican que adquieran genes específicos que les brinden tolerancia a ciertos agentes biocidas, existe también una respuesta de resistencia de tipo fisiológica -que otorga a las bacterias protección frente a un amplio abanico de peligros- a partir de la formación de estructuras denominadas biofilms que les permiten vivir en comunidad.
Se considera que más de la mitad de las bacterias patógenas que generan infecciones crecen en comunidades de biofilms. En este marco, un equipo del CONICET en el Instituto de Biología Molecular y Celular de Rosario (IBR, CONICET-UNR) bajo la dirección del investigador Diego Serra, busca, con resultados hasta ahora prometedores, compuestos que puedan inhibir la formación de estas estructuras protectoras, para que actúen en sinergia con otros antibióticos.
En los biofilms las bacterias crecen contenidas en una matriz fabricada por ellas mismas que les permite adherirse a superficies y congregarse en verdaderos ecosistemas que muchas veces, incluso, pueden estar formados por varios tipos de bacterias y hasta hongos unicelulares.
“Casi todas las bacterias tienen la capacidad de formar y vivir en biofilms; incluso se piensa en estas estructuras como el prototipo más antiguo de lo que luego con la evolución serían los organismos multicelulares, porque los biofilms funcionan como un tejido, con coordinación y división de tareas”, explica Serra, director del laboratorio de Estructura y Fisiología de Biofilms Microbianos en el IBR.
Esta organización requiere que las bacterias que se encuentran en el estrato superior del biofilm sean las productoras de grandes cantidades de los componentes que forman la matriz extracelular. Esto no solo es algo muy trabajoso y costoso energéticamente para estas bacterias, sino que, a medida que generan la matriz y protegen a las bacterias que se encuentran por debajo, también se alejan de la fuente de nutrientes.
Según explica Serra, cuando se quedan sin nutrientes, se estresan y utilizan sus últimos recursos para rodearse con un poco más de matriz y “dormirse”. Entonces “cuando un antibiótico se enfrenta a un biofilm, solo puede actuar sobre la capa inferior de bacterias que se encuentra en activo crecimiento cerca de los nutrientes, mientras que las bacterias dormidas de la capa superior sobreviven. Esto es un problema en el área clínica ya que entre un 50 y un 80 % de las infecciones están relacionadas con el crecimiento de las bacterias patógenas en comunidades de biofilms”, remarca.
Serra comenzó su formación en biotecnología en la Universidad Nacional del Litoral (UNL), para luego realizar un doctorado en la Universidad Nacional de La Plata (UNLP) que le permitió trabajar ocho años en la Universidad Humboltd en Berlin, Alemania. “En mi etapa formativa siempre me preocupé en entender cómo las bacterias se juntan y viven formando estos biofilms –relata Serra- cuando decido volver al país, quise combinar todos los conocimientos que teníamos sobre por qué y cómo las bacterias forman estas comunidades, para darle una aplicación en el ámbito de la salud, siento que es importante tener esta retribución hacia la sociedad y que la ciencia atienda estas problemáticas”.
En su laboratorio desarrollan dos líneas de investigación principales. Una dedicada a conocer los detalles sobre la tolerancia de los biofilms a las concentraciones letales de antibióticos para desarrollar estrategias efectivas para atacar a todas las bacterias dentro de la comunidad. Y otra que estudia los efectos de las concentraciones subletales de antibióticos sobre los biofilms.
Hay muchas circunstancias donde las bacterias quedan expuestas a concentraciones muy bajas de antibióticos. Según Estefanía Cordisco, investigadora del CONICET que realizó su trabajo posdoctoral en el laboratorio de Serra, un caso frecuente es cuando se administran antibióticos por vía oral. “Se toma una concentración muy alta calculando que luego de pasar por vía sistémica, llegue al sitio de acción la concentración efectiva. Pero, por un lado, no todos los organismos son iguales y en muchos casos ese antibiótico llega a una concentración reducida al sitio de la infección, y, por otro lado, están los efectos sobre otras bacterias no patógenas que viven en el organismo y también quedan expuestas a concentraciones bajas de antibiótico que les llega por el torrente sanguíneo”.
Por su parte, Serra advierte que también estas concentraciones subletales existen en el ambiente: “Se pueden detectar antibióticos en casi todos los ambientes, porque hay un abuso en el uso. En los ríos, por ejemplo, suele encontrarse antibióticos que llegan a través de efluentes industriales o como desechos de orina y heces derivados de la actividad ganadera, avícola e incluso de la piscicultura”.
La actividad de los antibióticos “bajo la luz de la luna”
El término moonlighting (derivado del inglés: luz de luna) fue acuñado en los años 50s por la sociología, para referirse a la actividad que realizaban los trabajadores que tenían un segundo empleo, usualmente nocturno, bajo la luz de la luna. En biología se empezó a usar para definir las funciones secundarias de ciertas proteínas.
“Se nos ocurrió que podíamos usar este término para sintetizar la diversidad de efectos que vemos que pueden tener los antibióticos, más allá de su principal función, que es matar a las bacterias”, indica Serra, quien junto a Cordisco fueron invitados por la revista Trends in Microbiology, del grupo Cell Press, para escribir un artículo donde recopilan, analizan y discuten las investigaciones previas y el estado del conocimiento actual sobre este tema, que ilustra la tapa de uno de los últimos número de la publicación.
“Sabemos que los antibióticos a concentraciones subletales generan una señal de estrés en las bacterias, y que, en la mayoría de los casos, promueven la generación del biofilm. Sin embargo, recientemente en nuestro laboratorio hemos demostrado que también puede darse el efecto contrario. Encontramos el caso de un antibiótico que inhibe la formación del biofilm. Estos casos excepcionales son buenos para definir nuevos mecanismos para explorar”, detalla.
Ocurrió mientras buscaban sustancias de origen microbiano que actuaran inhibiendo la formación de biofilms. Vieron que la especie Bacillus subtilis podía impedir la formación y el avance de otras bacterias creciendo en forma de biofilm. La sorpresa fue cuando lograron identificar cuál era la sustancia responsable de este efecto, y resultó ser un antibiótico llamado baciloína, que esta bacteria produce y libera naturalmente.
“Esto nos mostró que dependiendo del antibiótico y su mecanismo de acción los efectos podían ser muy diferentes. Al estudiar la interacción de baciloína a concentraciones subletales con el biofilm de la bacteria receptora, vimos que la baciloína puede inactivar la matriz del biofilm sin que la bacteria se dé cuenta, es decir, sin generar una señal de estrés”, relata Cordisco.
Serra explica que esto tiene un sentido ecológico muy claro cuando se plantea un escenario de competencia: “El bacilo libera la baciloína a su alrededor y si hay otro microorganismo a cierta distancia protegido en su biofilm, lo primero que hace es quitarle la protección de la matriz extracelular, provocando la desintegración del biofilm. Entonces, a medida que el bacilo sigue creciendo y se acerca al microorganismo desprotegido, puede finalmente eliminarlo y prevalecer”.
Aplicado al campo de la salud, “esto resulta interesante porque por síntesis química se podría obtener un compuesto que emule este comportamiento o incluso podrían implementarse tratamientos que combinen el uso de antibióticos con compuestos anti-biofilms”, concluye.
Fuente: CONICET.